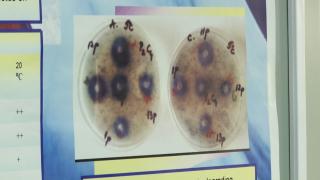
Val de conspiraţii după cazurile de lepră din Cluj. Informaţii false că oamenii sunt aduşi în secret la spital

Alex Prunean
Meseria aceasta de fapt e o vocație. Sau un microb. De fapt, ambele. Îmi aduc aminte că atunci când am intrat în “familia Antenei” eram cel mai tânăr corespondent. Timpul a trecut fără să îmi dau seama și am ajuns unul dintre cei vechi. Am filmat, am scris, am editat, montat și transmis în direct. Și sunt convins în continuare că biroul meu e pe teren. De ce am ales să fiu jurnalist? Cred că jurnalismul m-a ales pe mine, dar îmi plac dreptatea, adevărul și nu îmi plac oamenii care nu se țin de cuvânt. Pentru că, pentru mine, cuvântul e mai important decât orice.